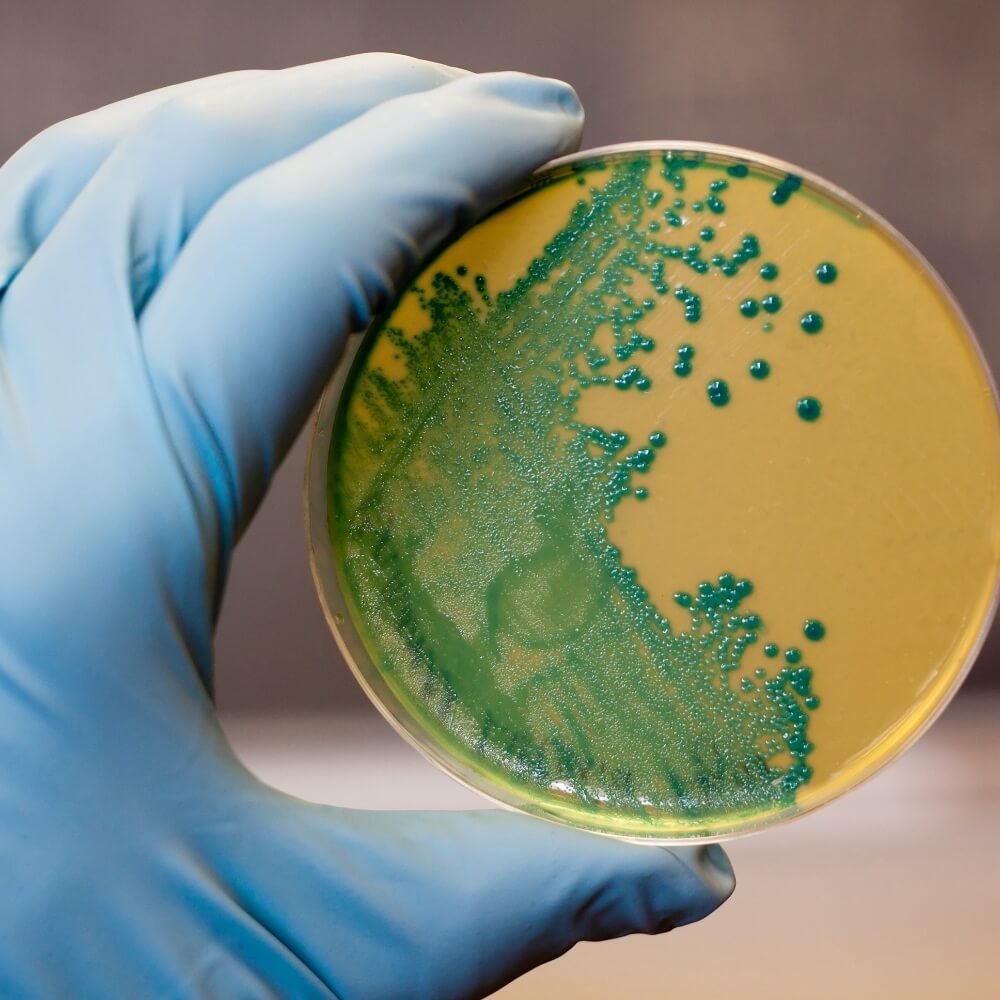

Bacteria and Other Biohazards Assessment
Our Company
Maqneecon claims the knowledge and experience to provide fast and economical solutions to a variety of environmental and project management challenges.
Our Services

